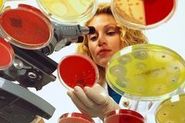

27.02.2015
г.Брянск, пр-т Ленина, д.72
(4832) 74-95-90
Консультации по вопросам защиты прав потребителей
8 (4832) 74-58-14

27.02.2015
24.02.2015

20.02.2015

18.02.2015

17.02.2015

13.02.2015

03.02.2015

02.02.2015
Пользователь, отправляя информацию через форму обратной связи на интернет-сайте https://bgcsen.bryansk.in, обязуется принять настоящее согласие на обработку персональных данных (далее – Согласие). Принятием (акцептом) оферты Согласия является нажатие на кнопку «Отправить» на любой странице интернет-сайта с формой обратной связи. Пользователь дает свое согласие ФБУЗ «Центр гигиены и эпидемиологии в Брянской области», которому принадлежит сайт https://bgcsen.bryansk.in и который расположен по адресу: 241050, г. Брянск, проспект Ленина, 72 на обработку своих персональных данных со следующими условиями:
1. Данное Согласие дается на обработку персональных данных, как без использования средств автоматизации, так и с их использованием.
2. Согласие дается на обработку следующих персональных данных:
3. Цель обработки персональных данных - ответы на запросы и обращения пользователей интернет-сайта.
4. Основанием для обработки персональных данных являются действующее законодательство Российской Федерации и настоящее Согласие на обработку персональных данных.
5. В ходе обработки с персональными данными могут быть совершены следующие действия: сбор, запись, систематизация, накопление, хранение, уточнение (обновление, изменение), передача (предоставление, доступ), извлечение, использование, блокирование, удаление, уничтожение.
6. Передача персональных данных третьим лицам не осуществляется.
7. Настоящее Согласие вступает в силу с момента его принятия и действует до момента его отзыва.
8. Согласие может быть отозвано субъектом персональных данных или его представителем, путем направления письменного заявления ФБУЗ «Центр гигиены и эпидемиологии в Брянской области» или его представителю по адресу, указанному в начале данного Согласия.
9. В случае отзыва субъектом персональных данных или его представителем согласия на обработку персональных данных ФБУЗ «Центр гигиены и эпидемиологии в Брянской области» вправе продолжить обработку персональных данных без согласия субъекта персональных данных при наличии оснований в соответствии с Федеральным законом от 27.07.2006 №152-ФЗ «О персональных данных».